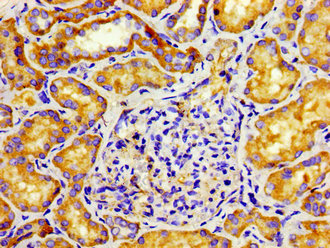

CD207 Antibody
-
中文名稱:CD207兔多克隆抗體
-
貨號:CSB-PA892321LA01HU
-
規(guī)格:¥440
-
圖片:
-
Immunohistochemistry of paraffin-embedded human melanoma using CSB-PA892321LA01HU at dilution of 1: 100
-
Immunohistochemistry of paraffin-embedded human kidney tissue using CSB-PA892321LA01HU at dilution of 1: 100
-
Immunofluorescent analysis of MCF-7 cells using CSB-PA892321LA01HU at dilution of 1: 100 and Alexa Fluor 488-congugated AffiniPure Goat Anti-Rabbit IgG(H+L)
-
-
其他:
產(chǎn)品詳情
-
產(chǎn)品名稱:Rabbit anti-Homo sapiens (Human) CD207 Polyclonal antibody
-
Uniprot No.:
-
基因名:CD207
-
別名:C type lectin domain family 4 member K antibody; C-type lectin domain family 4 member K antibody; CD 207 antibody; CD207 antibody; CD207 antigen antibody; CD207 antigen; langerin antibody; CD207 molecule antibody; CLC4K_HUMAN antibody; CLEC 4K antibody; CLEC4K antibody; Langerhans cell specific c type lectin antibody; Langerin antibody; RGD1565913 antibody
-
宿主:Rabbit
-
反應(yīng)種屬:Human
-
免疫原:Recombinant Human C-type lectin domain family 4 member K protein (229-312AA)
-
免疫原種屬:Homo sapiens (Human)
-
標(biāo)記方式:Non-conjugated
本頁面中的產(chǎn)品,CD207 Antibody (CSB-PA892321LA01HU),的標(biāo)記方式是Non-conjugated。對于CD207 Antibody,我們還提供其他標(biāo)記。見下表:
-
克隆類型:Polyclonal
-
抗體亞型:IgG
-
純化方式:>95%, Protein G purified
-
濃度:It differs from different batches. Please contact us to confirm it.
-
保存緩沖液:Preservative: 0.03% Proclin 300
Constituents: 50% Glycerol, 0.01M PBS, pH 7.4 -
產(chǎn)品提供形式:Liquid
-
應(yīng)用范圍:ELISA, IHC, IF
-
推薦稀釋比:
Application Recommended Dilution IHC 1:20-1:200 IF 1:50-1:200 -
Protocols:
-
儲存條件:Upon receipt, store at -20°C or -80°C. Avoid repeated freeze.
-
貨期:Basically, we can dispatch the products out in 1-3 working days after receiving your orders. Delivery time maybe differs from different purchasing way or location, please kindly consult your local distributors for specific delivery time.
-
用途:For Research Use Only. Not for use in diagnostic or therapeutic procedures.
相關(guān)產(chǎn)品
靶點(diǎn)詳情
-
功能:Calcium-dependent lectin displaying mannose-binding specificity. Induces the formation of Birbeck granules (BGs); is a potent regulator of membrane superimposition and zippering. Binds to sulfated as well as mannosylated glycans, keratan sulfate (KS) and beta-glucans. Facilitates uptake of antigens and is involved in the routing and/or processing of antigen for presentation to T cells. Major receptor on primary Langerhans cells for Candida species, Saccharomyces species, and Malassezia furfur. Protects against human immunodeficiency virus-1 (HIV-1) infection. Binds to high-mannose structures present on the envelope glycoprotein which is followed by subsequent targeting of the virus to the Birbeck granules leading to its rapid degradation.
-
基因功能參考文獻(xiàn):
- Binding analysis between purified long and short forms of langerin and a series of keratin sulfate disaccharide components shows that the binding critically requires the 6-sulfation of Gal and that the long form of langerin displays higher affinity than the short form. PMID: 29631057
- CD207(+)CD1a(+) cells are circulating in patients with active Langerhans cell histiocytosis, and TSLP and TGF-beta are potential drivers of Langerhans-like cells in vivo. PMID: 28847997
- the data provide evidence that human Langerhans cells are able to cross-present antigens after langerin-mediated internalization. PMID: 26456691
- Calcium-independent activation of an allosteric network in langerin by heparin oligosaccharides has been reported. PMID: 28198086
- Bacterial Polysaccharide Specificity of the Pattern Recognition Receptor Langerin Is Highly Species-dependent PMID: 27903635
- Kinetic and Structural Studies of Interactions between Glycosaminoglycans and Langerin PMID: 27447199
- We suggest that CD207 gene polymorphisms rs13421115 and rs17718987 increase the risk of development of end-stage renal disease. PMID: 27234728
- This study shows that mutations in the Langerin gene are present in the analysed populations at different genotypic and allelic frequencies and further studies should be conducted to verify the role of these mutations in HIV-1 susceptibility. PMID: 24676666
- This study is the first to demonstrate that langerin represents an authentic receptor that binds and internalizes influenza A virus to facilitate infection. PMID: 26468543
- Data suggest that Langerin (CD207)-mediated binding of Yersinia pestis to antigen-presenting cells (APCs) may promote its dissemination and infection. PMID: 25829141
- Langerin binds heparin (HEP)-like oligosaccharides in two different binding sites depending on the ligand size. PMID: 25747117
- The authors not only show that langerin and caveolin-1 co-localize at the cell membrane and in vesicles but that caveolin-1 mediated HIV-1 uptake is an intrinsic restriction mechanism present in human Langerhans cells that prevents HIV-1 infection. PMID: 25551286
- The impact of two carbohydrate recognition domains mutations, W264R and F241L, on langerin structure, function, and Birbeck granules assembly. PMID: 25650933
- Langerin is not expressed by freshly isolated CD1c(+) blood DCs but is rapidly induced on CD1c(+) DCs by serum or TGF-beta via an ALK-3-dependent pathway. PMID: 25516751
- Cell-sorting experiments demonstrated that IDO1 expression is found in a subset of CD1a(+)CD14(-)langerin(+) cells, expressing CD103 PMID: 25584868
- However, the superoxide dismutase C (SodC) protein of the Mycobacterium leprae cell wall was identified as a langerin-reactive ligand. PMID: 25422308
- Both phases of HIV transfer from eLCs to T cells were inhibited when eLCs were pretreated with a mAb to langerin CRD or when HIV was pretreated with a soluble langerin trimeric extracellular domain or by a CRD homolog. PMID: 25070850
- Altered langerin function in individuals with the linked N288D and K313I polymorphisms may affect susceptibility to infection by microorganisms. PMID: 24217250
- binding properties of langerin PMID: 23226363
- A langerin-cre recombinase transgenic knockin mouse strain is generated that efficiently targets Langerhans cells and other langerin-positive dendritic cells, in particular, in the dermis and the lung. PMID: 21998450
- measles virus receptor on Langergans cells PMID: 21739428
- Unlike selective Langerhans cell deficiency, ablation of all langerin-positive dendritic cells abrogates activation of IFN-gamma-producing and cytolytic CD8-positive T cells following gene gun vaccination. PMID: 21187444
- Crystal structures of the carbohydrate-recognition domain from langerin bound to oligomannoses, blood group B antigen, and a fragment of beta-glucan reveal binding to mannose, fucose, and glucose by Ca(2+) coordination of hydroxyl groups. PMID: 21112338
- Activation of CD8-positive T cells following intradermal plasmid DNA immunization depends on directly transfected langerin-positive dermal dendritic cells and dermal DCs. PMID: 20713888
- Trimeric structure of langerin. PMID: 20181944
- Langerin mediates diverse functions on Langerhans cells through dual recognition of sulfated as well as mannosylated glycans by its uniquely evolved C-type carbohydrate-recognition domain PMID: 20026605
- Langerin is the major fungal pathogen receptor on human Langerhans cells that recognizes pathogenic and commensal fungi. PMID: 20097424
- Data show that the expression of CD1a and CD207 is markedly down-regulated in CA epidermis. PMID: 19426597
- In a transgenic mouse model, the langerin-expressing subset of CD8alpha-positive dendritic cells is crucially involved in priming and differentiation of responses to cross-presented antigen. PMID: 19923446
- langerin was expressed by Langerhans cells PMID: 12352970
- Langerin is a potent langerhans cells -specific regulator of membrane superimposition and zippering, representing a key molecule to trace Langerhans cells [Review]. PMID: 14610287
- CD1a and langerin have roles in antigen presentation to T cells PMID: 14991068
- The Langerin-positive cells strictly colonized the epidermis and no cells were found in the dermis. PMID: 15222130
- Expression of mutated Langerin in human fibroblasts induces tubular-like structures that are negative for Birbeck granules-specific antibodies and do not resemble the characteristic structural features of Birbeck granules. PMID: 15816828
- Electron microscopy analysis demonstrated a colocalization of human papillomavirus 16 virus-like particles and langerin, which is expressed only by Langerhans cells PMID: 15831940
- The effects of the amino acid changes on the activity of langerin were examined by expressing each of the polymorphic forms. PMID: 16567809
- Langerin prevents HIV-1 transmission by Langernhans cells. PMID: 17334373
- Langerin transgenic mice have substantially reduced numbers of epidermal langerhans cells, demonstrating that TGFbeta1 acts directly on these cells. PMID: 17938236
- The carbohydrate-recognition domain of human Langerin was crystallized followed by X-ray analyses to resolutions of 2.5A for apo-Langerin and to 1.6A and 2.1A for the complexes with mannose and maltose, respectively. PMID: 18061677
- overproduction, purification and crystallization of the langerin carbohydrate binding domain is reported PMID: 18259063
- Immunohistochemical evaluation of langerin expression may have utility in substantiating a diagnosis of Langerhans cell histiocytosis and separating this disorder from other non-Langerhans cell histiocytic proliferations. PMID: 18277880
- Transgenic langerin effectively mediates antigen presentation in vivo by targeting its receptor in appropriate mouse dendritic cell subsets of draining lymph nodes and spleen; peptide major histocompatibility I and II complexes persist for days. PMID: 18322168
顯示更多
收起更多
-
相關(guān)疾病:Birbeck granule deficiency (BIRGD)
-
亞細(xì)胞定位:Membrane; Single-pass type II membrane protein. Note=Found in Birbeck granules (BGs), which are organelles consisting of superimposed and zippered membranes.
-
組織特異性:Exclusively expressed by Langerhans cells. Expressed in astrocytoma and malignant ependymoma, but not in normal brain tissues.
-
數(shù)據(jù)庫鏈接:
Most popular with customers
-
-
YWHAB Recombinant Monoclonal Antibody
Applications: ELISA, WB, IHC, IF, FC
Species Reactivity: Human, Mouse, Rat
-
Phospho-YAP1 (S127) Recombinant Monoclonal Antibody
Applications: ELISA, WB, IHC
Species Reactivity: Human
-
-
-
-
-